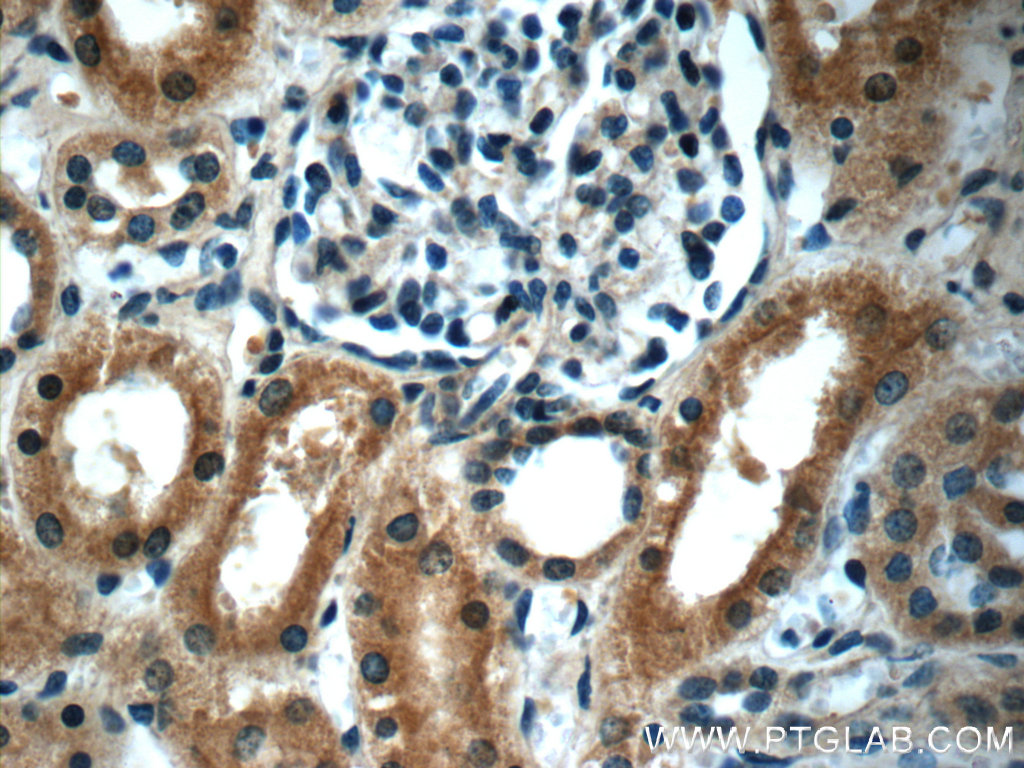

验证数据展示
产品信息
60063-1-PBS targets Stanniocalcin 2 as part of a matched antibody pair:
MP50715-1: 60063-1-PBS capture and 60063-2-PBS detection (validated in Cytometric bead array)
Unconjugated mouse monoclonal antibody pair in PBS only (BSA and azide free) storage buffer at a concentration of 1 mg/mL, ready for conjugation.
This conjugation ready format makes antibodies ideal for use in many applications including: ELISAs, multiplex assays requiring matched pairs, mass cytometry, and multiplex imaging applications.Antibody use should be optimized by the end user for each application and assay.
| 经测试应用 | WB, IHC, IF/ICC, Cytometric bead array, Indirect ELISA Application Description |
| 经测试反应性 | human, mouse, pig |
| 免疫原 |
CatNo: Ag0359 Product name: Recombinant human STC2 protein Source: e coli.-derived, PGEX-4T Tag: GST Domain: 11-291 aa of BC000658 Sequence: TLALVLATFDPARGTDATNPPEGPQDRSSQQKGRLSLQNTAEIQHCLVNAGDVGCGVFECFENNSCEIRGLHGICMTFLHNAGKFDAQGKSFIKDALKCKAHALRHRFGCISRKCPAIREMVSQLQRECYLKHDLCAAAQENTRVIVEMIHFKDLLLHEPYVDLVNLLLTCGEEVKEAITHSVQVQCEQNWGSLCSILSFCTSAIQKPPTAPPERQPQVDRTKLSRAHHGEAGHHLPEPSSRETGRGAKGERGSKSHPNAHARGRVGGLGAQGPSGSSEWE 种属同源性预测 |
| 宿主/亚型 | Mouse / IgG1 |
| 抗体类别 | Monoclonal |
| 产品类型 | Antibody |
| 全称 | stanniocalcin 2 |
| 别名 | STC2, 4H1E7, Stanniocalcin related protein, Stanniocalcin-2, Stanniocalcin-related protein |
| 计算分子量 | 33 kDa |
| 观测分子量 | 44 kDa |
| GenBank蛋白编号 | BC000658 |
| 基因名称 | Stanniocalcin 2 |
| Gene ID (NCBI) | 8614 |
| RRID | AB_2197544 |
| 偶联类型 | Unconjugated |
| 形式 | Liquid |
| 纯化方式 | Protein G purification |
| UNIPROT ID | O76061 |
| 储存缓冲液 | PBS only, pH 7.3. |
| 储存条件 | Store at -80°C. The product is shipped with ice packs. Upon receipt, store it immediately at -80°C |
背景介绍
Stanniocalcin (STC) is a family of secreted glycoprotein hormones that originally discovered in the corpuscles of Stannius, an endocrine gland of fish. STC1 and STC2, two homologues of STC family, are reported to involve in calcium and phosphate homeostasis. It is expressed in a wide variety of tissues such as kidney, spleen, heart, and pancreas. The protein may play a role in the regulation of renal and intestinal calcium and phosphate transport, cell metabolism, or cellular calcium/phosphate homeostasis. STC2 overexpression could promote tumor cell proliferation, invasion and metastasis in prostate cancer, ovarian cancer or neuroblastoma. STC2 is also vital for cytoprotective properties when exposed to ER stress and hypoxia.